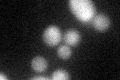

View description
Protein involved in nuclear migration, part of the dynein/dynactin pathway; targets dynein to microtubule tips, which is necessary for sliding of microtubules along bud cortex; synthetic lethal with bni1; homolog of human LIS1
Localization:
Intensity:
Fold change:
Significance:
-
C’ GFP library in SD

below threshold17.07 -
N' NOP1pr-GFP in SD

cytosol,nucleus51.6838 -
N' TEF2pr-mCherry in SD

cytosol58.0156 -
N' NATIVEpr-GFP in SD

below threshold18.6746 -
N' TEF2pr-VC and Cyto-VN in SD

#N/A0 -
C’ GFP library in SD+DTT
cytosol19.841.16No -
C’ GFP library in SD+H2O2

cytosol19.041.11No -
C’ GFP library in Starvation Media

cytosol15.30.89No -
C’ GFP library on the background of Pup2-DaMP

N/A -
C’ GFP library on the background of CCT mutant

N/A0N/AYes
